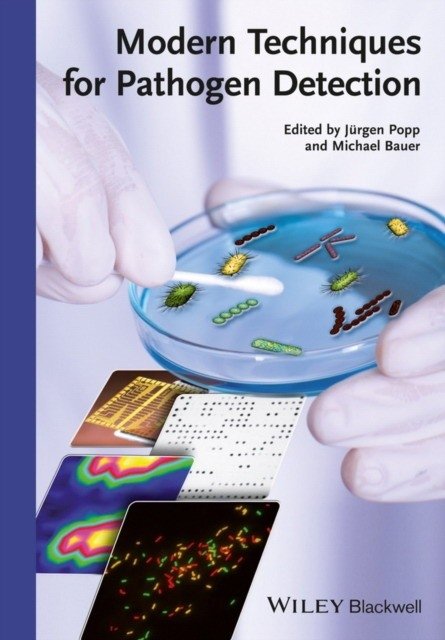
Современные методы обнаружения патогенов | Modern Techniques for Pathogen Detection
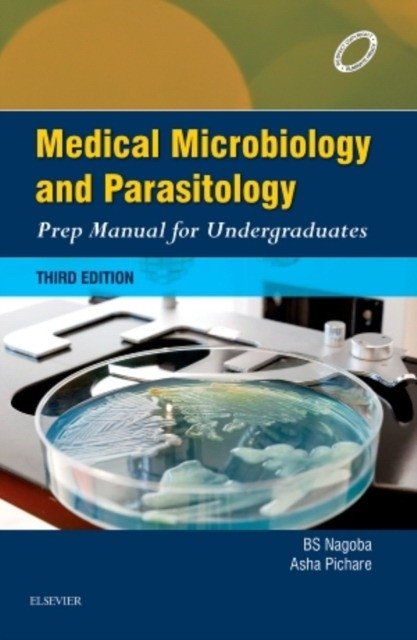
Medical Microbiology and Parasitology: Prep Manual for Undergraduates, 3/e | Medical Microbiology and Parasitology: Prep Manual for Undergraduates, 3rd Edition

Discover the |
RusLibrary, your premier destination for Russian books, brings you the finest collection of classic and contemporary literature. From Tolstoy to modern authors, explore thousands of titles with worldwide delivery.
Curated Series
Classic Russian Literature Collection
Immerse yourself in Dostoevsky, Pushkin, Chekhov and other literary greats. Fresh picks from the “Классика для школьников” series are surfaced each visit.

Тринадцатый подвиг Геракла | Hercules' Thirteenth Labor
Искандер Фазиль Абдулович

Сказка о Мальчише-Кибальчише. Рассказы | The Tale of Malchish-Kibalchish and Other Stories
Гайдар Аркадий Петрович

Динка | Dinka
Осеева Валентина Александровна

Путешествие Алисы | Alice's Journey
Кир Булычев

Приключения Электроника | The Adventures of Elektronik
Велтистов Евгений Серафимович

Ночевала тучка золотая | The Golden Cloud Spent the Night
Приставкин Анатолий Игнатьевич

Чучело | Scarecrow
Железников Владимир Карпович

Четвертая высота | The Fourth Height
Ильина Елена Яковлевна

Белый Бим чёрное ухо | White Bim Black Ear
Троепольский Гавриил Николаевич , …

Левша | Lefty
Лесков Николай Семенович

Двадцать тысяч лье под водой | Twenty Thousand Leagues Under the Sea
Жюль Верн

Пастух и пастушка. Повести и рассказы | The Shepherd and the Shepherdess. Stories and Tales
Виктор Астафьев
For Young Readers
Children’s Literature
Picture books, bedtime stories and learning companions to inspire curiosity at every age.

Зачем белке хвост | Why Does a Squirrel Need a Tail
Баруздин Сергей Алексеевич

Почему так много "почему". Сказки о природе | Why Are There So Many "Whys"? Fairy Tales About Nature
Дружков Юрий Михайлович

Друзья | Friends
Чарушин Евгений Иванович

Еня и Еля. Зимние истории | Enya and Elya. Winter Stories
Гончарова Анна Сергеевна

Записки охотника. Рассказы | A Hunter's Sketches. Stories
Тургенев Иван Сергеевич

Сказки и рассказы о животных | Animal Tales and Stories
Коваль Юрий Иосифович , …

Вот они какие | Here They Are
Чарушин Евгений Иванович

Морские истории | Sea Stories
Борис Житков

Рассказы о природе | Stories about Nature
Соколов-Микитов Иван Сергеевич

Рассказы о животных | Animal Stories
Куприн Александр Иванович

Необыкновенные приключения Карика и Вали | The Extraordinary Adventures of Karlik and Vali
Ларри Ян Леопольдович

Белый пудель | The White Poodle
Куприн Александр Иванович

Лесные сказки | Forest Tales
Виталий Бианки

Рассказы о родной природе | Stories about Native Nature
Паустовский Константин Георгиевич
Featured Fiction
Fiction & Classics
Novels, short stories and timeless epics from Russian masters and global voices alike.

Мой первый круиз | My First Cruise
Лавринович Ася

Комплект из двух книг: Загадай любовь + Сказка о снежной принцессе | Two-Book Set: Make a Wish for Love + The Tale of the Snow Princess
Лавринович Ася

Комплект из двух книг: Любовь не по сценарию + Загадай любовь | Love Off-Script + Make a Wish for Love: Two-Book Set
Лавринович Ася

Комплект из двух книг: Мой первый круиз + В поисках сокровища | Two-Book Set: My First Cruise + In Search of Treasure
Лавринович Ася

Мертвый рассвет | Dead Dawn
Ройдон Вики

Комплект из двух книг: Там, где живет любовь + Ты мое счастье | Where Love Lives + You Are My Happiness: Two-Book Set
Лавринович Ася

Легенда о вампирах. Диаблери | Legend of Vampires: Diablerie
Ана Шерри

Светя другим — сгораю | Burning While Lighting Others
Морозова Александра

Комплект из трех книг: Косточка с вишней + Планы на лето + Только попробуй уйти | Three-Book Set: A Cherry Pit, Summer Plans, Just Try to Leave
Лавринович Ася

Комплект из двух книг: Планы на лето + Косточка с вишней | Two-Book Set: Summer Plans + The Cherry Pit
Лавринович Ася

Комплект из трех книг: Там, где живет любовь + Ты мое счастье + Нелюбовь сероглазого короля | Three-Book Set: Where Love Lives + You Are My Happiness + The Seroglaz King's Dislike
Лавринович Ася

Комплект из двух книг: Это снова ты + Она любит плохих парней | Two-Book Set: It's You Again + She Loves Bad Boys
Хилл Алекс

Любовь под напряжением | Love Under Voltage
Лавринович Ася

Комплект из двух книг: Только попробуй уйти + Мой первый круиз | Two-Book Set: Just Try to Leave + My First Cruise
Лавринович Ася
Curious Minds
Science & Knowledge
Popular science, research and educational titles that decode the world around us.

Биология за 30 секунд: 50 самых интригующих теорий о жизни, рассказанных за 30 секунд | Biology in 30 Seconds: 50 Intriguing Theories About Life, Explained in 30 Seconds
Клегг Брайан , …

Вот зараза. Что такое вирусы, как с ними бороться и уживаться | The Nuisance: What Viruses Are, How to Fight Them and Coexist
Нечипоренко Юрий Дмитриевич , …

Medical Microbiology, Virology, Immunology. Volume 2 | Medical Microbiology, Virology, Immunology. Volume 2
Зверев Виталий Васильевич

Вирусы и микробы. Умные окошки | Viruses and Microbes: Smart Windows

Человек на бактериях. Как получить силу и энергию из своего кишечника | Humanity on Bacteria: Gaining Strength and Energy from Your Gut
Коссобудзка Маргит

Вирусы и микробы. Научный комикс | Viruses and Microbes: A Science Comic
Кох Фалинн

Одинаковые или разные? Геномика | Same or Different? Genomics
Майонеро Франсиско Хавьер Соберон

Эволюционная эпистемология. Антология | Evoliutsionnaia epistemologiia. Antologiia
Князева Е.

COVID-19: от этиологии до вакцинопрофилактики. Руководство для врачей | COVID-19: From Etiology to Vaccination. A Guide for Physicians
Бургасова Ольга Александровна , …

Вирусы и эпидемии в истории мира | Viruses and Epidemics in World History
Олдстоун М.

Вселенная внутри нас. Как микробы обогащают наш взгляд на жизнь | The Universe Within Us: How Microbes Enrich Our View of Life
Йонг Эд

Микробиология, вирусология и иммунология. Руководство к лабораторным занятиям | Microbiology, Virology, and Immunology: A Laboratory Manual
Под ред. Сбойчакова В.Б. , …

Основы микробиологии и инфекционная безопасность. Лабораторный практикум. Учебное пособие | Fundamentals of Microbiology and Infectious Safety: Laboratory Practicum
Остапова Т.С. , …

Академики против вирусов. Что нас ждет завтра? | Academics vs. Viruses: What Awaits Us Tomorrow?
Губарев Владимир
Read Globally
World Languages
Original language editions and translations for polyglots, students and curious readers.

Oxford Handbook of Clinical Specialties | Oxford Handbook of Clinical Specialties

Патофизиология заболевания: Введение в клиническую медицину 7 IE | Pathophysiology of Disease: An Introduction to Clinical Medicine 7 IE

Neuroanaesthesia | Neuroanaesthesia: A Concise Guide

Pharmacotherapy Principles & Practice. 2007 | Pharmacotherapy Principles & Practice
Chisholm-Burns

Medical Emergencies in Children, Revised 5e (HB) | Medical Emergencies in Children, Revised 5e (Hardback)
Meharban Singh

Beyond Order HB | Beyond Order
Peterson Jordan B

Практика ультразвукового исследования молочной железы: Методики, находки, дифференциальная диагностика | The Practice of Breast Ultrasound: Techniques, Findings, Differential Diagnosis
Helmut Madjar

Diagnostic Endosonography | Diagnostic Endosonography

Редкие и редкие гинекологические раки | Rare and Uncommon Gynecological Cancers
Reed

Введение в расстройства коммуникации: Перспектива, основанная на доказательствах на протяжении всей жизни | Introduction to Communication Disorders: A Lifespan Evidence-Based Perspective
Owens Robert E.
Современные методы обнаружения патогенов | Modern Techniques for Pathogen Detection

Radiotherapy for Non-Malignant Disorders | Radiotherapy for Non-Malignant Disorders
Medical Microbiology and Parasitology: Prep Manual for Undergraduates, 3/e | Medical Microbiology and Parasitology: Prep Manual for Undergraduates, 3rd Edition
Nagoba B. S.

Study guide to accompany pathophysiology | Study Guide to Accompany Pathophysiology
Braun Carie
For Professionals
Business & Strategy
Leadership playbooks, entrepreneurial insights and economic analysis for ambitious teams.

Команда 101
Максвелл Джон

Жесткие коммерческие переговоры. Как прочитать оппонента и просчитать все риски | Tough Business Negotiations: Reading Your Opponent and Calculating Risks
Илюха Сергей Александрович

Менеджмент. Природа и структура организаций
Минцберг Генри

Кармический менеджмент: эффект бумеранга в бизнесе и в жизни
Роуч Мэри

Искусство управленческой борьбы (карманное издание). Технологии перехвата и удержания управления
Тарасов Владимир Константинович

Библия менеджмента
Нельсон Б. , …

50 советов по рекрутингу | 50 Recruitment Tips
Иванова Светлана

Пока псы лают, коты побеждают: Менеджмент без догм
Шерман Л.

Риск-менеджмент. Принципы и методики | Risk Management: Principles and Methods
Дамодаран Асват

В какой стае вырос ваш босс? Как выжить в корпоративной "пищевой цепи" | What Pack Did Your Boss Grow Up In? How to Survive the Corporate "Food Chain"
Гро Дж. М.

Выживают только параноики: как использовать кризисные периоды, с которыми сталкивается любая компания
Гроув Эндрю

Команда для лидера, лидер для команды. Как добиваться синергии, управлять мотивацией и масштабировать результаты
Канавина Е.А.

Как преодолеть кризисы менеджмента: Диагностика и решение управленческих проблем
Адизес Ицхак Калдерон

Отчаянные аккаунт-менеджеры. Как работать с клиентами без стресса и проблем. Настольная книга аккаунт-менеджера, менеджера проектов и фрилансера
Шпирт Б.
Hidden Knowledge
Mysticism & Esoterica
Astrology, tarot, parapsychology and other guides for seekers of the unseen.

Новое руководство по картам Таро | New Tarot Card Guide
Поллак Р.

Спроси ведьму. Карты, которые знают о тебе все (подарочная) | Ask the Witch: Cards That Know Everything About You (Gift Edition)
Ивлиева Юлия Андреевна

Таро Сефиротическая магия. Сила Древа Жизни | Tarot: Sephirotic Magic. The Power of the Tree of Life
Журавлев Николай Борисович

Священная книга Тота. Великие арканы Таро | The Sacred Book of Thoth: The Major Arcana of Tarot
Шмаков В.А.

Таро Уэйта. Эффективное обучение: от новичка до мастера. 78 карт с подсказками на картах + 50 раскладов | Waite Tarot: Effective Learning from Beginner to Master
Вэйт Августа

Классическое Таро Уэйта для начинающих. Подробное руководство для самостоятельного обучения | The Classic Waite Tarot for Beginners: A Detailed Self-Study Guide
Леванов Эдуард Владимирович

Dark Idol Tarot. Таро темных историй | Dark Idol Tarot. Tarot of Dark Stories
Адамс Сабрина

Мистический Оракул Меламори. Карты, указывающие путь и дающие глубинные ответы | Melamori's Mystical Oracle: Cards for Guidance and Deep Answers
Меламори Ксения

Таро Уэйта. Символика и толкование карт | Waite Tarot: Symbolism and Interpretation
Огински Анна

Набор Гадания: Гордость и предубеждение | Divination Set: Pride and Prejudice
Джейн Остин

Гримуар Таро. Магия карт, символов и предсказаний | Grimoire of Tarot: Magic of Cards, Symbols, and Predictions
Ким Элис

Оракул Агарты. Послания древних народов | Oracle of Agartha: Messages from Ancient Peoples
Лулюминез Л.

Таро Уэйта. Уникальное толкование карт от признанного Мастера. Глубоко, подробно, понятно | The Waite Tarot: Unique Interpretation by a Master
Вэлс Мартин

Таро культовых героев (78 карт и руководство к колоде) | Tarot of Cult Heroes (78 Cards and Guidebook)
Демонси Беранжер
Live Well
Wellness & Self-Care
Mindfulness, fitness and holistic health titles to support everyday wellbeing.

Гормоны и женское здоровье. Советы эндокринолога | Hormones and Women's Health: An Endocrinologist's Advice
Румянцева Татьяна

Тазовое дно - наше великое неизвестное | The Pelvic Floor: Our Great Unknown
Лопес Ракель , …

Гормон - и с чем его едят. Рецепты женского здоровья | Hormones: What They Are and How to Manage Them for Women's Health
Киркпатрик Белинда , …

Спросим гинеколога. Все, что вы хотели знать о месячных, сексе, предохранении и беременности | Ask a Gynecologist: Your Guide to Periods, Sex, Contraception, and Pregnancy
Линкольн Дженнифер

Сань-инь-цзяо и другие целительные точки для мужского и женского здоровья | Sanyinjiao and Other Healing Points for Male and Female Health
Лао Минь

Критические дни или 100 вопросов и ответов на эту тему | Menstruation: 100 Questions and Answers
Гардман Юлия Сергеевна

Зажги свой внутренний свет. Как научиться слушать себя и привлечь на свою орбиту всё, что захочешь | Ignite Your Inner Light. Learning to Listen to Yourself and Attract Everything You Desire
Томас Лейтем

Школа женского здоровья. Преврати свое тело в источник удовольствия, позаботившись о нем | The School of Women's Health: Turn Your Body into a Source of Pleasure by Caring for It

Книга упражнений для прокачки мышц тазового дна. Французская система полного физического восстановления для женщин | Pelvic Floor Muscle Training Exercise Book: French System for Complete Physical Recovery for Women
Кале-Жермен Бландин

Система Сосновского. 30 советов | Sosnovsky System. 30 Tips
Сосновский Александр

Viva la vagina. Хватит замалчивать скрытые возможности органа, который не принято называть | Viva la Vagina: Stop Silencing the Hidden Potential of the Organ We Don't Name
Брокманн Нина , …

Новая фаза. Как обрести эмоциональный комфорт в период менопаузы | New Phase: Finding Emotional Comfort During Menopause
Ашер Кейт

Энциклопедия здоровья женщины | Encyclopedia of Women's Health
Эммер Кристиан

Все, что нужно знать о женском здоровье. 1000 ответов на самые актуальные вопросы | Everything You Need to Know About Women's Health: 1000 Answers to Pressing Questions
Березовская Елена Петровна
For Every Day
Home & Lifestyle
Practical guides, hobbies and inspiration for a cozy, creative household.

Моя собака - сатана. Нескучный справочник для нервных собаководов | My Dog is Satan: A No-Nonsense Guide for Nervous Dog Owners
Подкосова Юлия Константиновна

Ко мне! Как научить собаку моментально возвращаться по команде | Come! How to Teach Your Dog to Return Instantly on Command
Романова Татьяна Владимировна

Американский кокер-спаниель | American Cocker Spaniel
Дубров М.

Главная книга владельца лабрадора | The Labrador Owner's Essential Guide
Панкратьева О.В., Тесленко О.А.

Фу! Моя собака-пылесос, или Как научить собаку не подбирать еду на улице | No! My Vacuum Cleaner Dog, or How to Teach Your Dog Not to Pick Up Food Outside
Романова Татьяна Владимировна

Азбука собачника. Иллюстрированное руководство по содержанию и воспитанию собаки | The Dog Owner's Alphabet: An Illustrated Guide to Dog Care and Training
Романова Татьяна Владимировна

Счастье на четырех лапах. Как стать лучшим другом для своей собаки | Four-Legged Happiness: Becoming Your Dog's Best Friend
Фафа Микаэль

Ньюфаундленд | Newfoundland
Бендьюр Джоан К.

Чушь собачья. Как не испортить удовольствие от появления собаки в твоей жизни | Dog Nonsense: How Not to Spoil the Joy of Getting a Dog
Макаренкова Ирина Владимировна

Доберман-пинчер | Doberman Pinscher
Уокер Джоанна

Породы собак. Определитель | Dog Breeds: A Guide
Михальская Анна Константиновна

Собаки. Популярный иллюстрированный гид | Dogs: A Popular Illustrated Guide
Барановская Ирина Геннадьевна, Вайткене Любовь Дмитриевна, Хомич Елена Олеговна

Американский бульдог | American Bulldog
Угольников Константин Владимирович

Собаки в городах. Жизнь собак в истории, искусстве и обществе | Dogs in Cities: Canine Life Through History, Art, and Society
Барыкова Мария Николаевна
Faith & Philosophy
Spiritual Reflections
Sacred texts, commentary and inspirational writing spanning diverse traditions.

Вера и доверие. Дар и прощение | Faith and Trust: Gift and Forgiveness
Бьянки Энцо

Победа над одиночеством | Victory Over Loneliness
Медведев Тимофей Ленарович

Проповеди. В 2-х книгах | Propovedi. V 2-kh knigakh
Таулер И.

Евангелие от Фомы. Апокрифы ранних христиан | The Gospel of Thomas. Apocrypha of the Early Christians
Пейджелс Элейн

Христос с тысячью лиц. Книга 2 | Christ with a Thousand Faces. Book 2
Латынина Юлия Леонидовна

Фома. Франциск. Ортодоксия | Foma. Frantsisk. Ortodoksiia
Честертон Гилберт Кит

Об истинном монашестве | Ob istinnom monashestve
Бендас Константин Владимирович

Серафим Саровский. Избранные духовные наставления, утешения и пророчества | Serafim Sarovskii. Izbrannye dukhovnye nastavleniia, utesheniia i prorochestva
Преподобный Серафим Саровский

Актуальная практика присоединения отпавших от Церкви | Aktual'naia praktika prisoedineniia otpavshikh ot Tserkvi

Сын Человеческий | The Son of Man
Мень Александр Владимирович

Вечный человек | Vechnyi chelovek
Честертон Гилберт Кийт

Экзорцист Ватикана. Более 160 000 сеансов изгнания дьявола | The Vatican Exorcist: Over 160,000 Exorcisms
Аморт Г. , …

Тёмная история католической церкви: Схизмы, войны, инквизиция, охота на ведьм, скандалы и коррупция | A Dark History of the Catholic Church: Schisms, Wars, Inquisition, Witch Hunts, Scandals, and Corruption
Керриган Майкл

Агапа. 12 языков любви | Agapa. 12 iazykov liubvi
Росси Марчелло
Creative Spotlight
Arts & Culture
Monographs, criticism and lavish editions celebrating visual arts, music and theatre.

Слуга Бельфегора. Рассказы о драгоценных камнях | Sluga Bel'fegora. Rasskazy o dragotsennykh kamniakh
Тюленев Сергей Львович

Драгоценные камни | Gemstones
Пыляев Михаил Иванович

Основы анимации в Spine 2D для начинающих. Как создавать крутые игры без гигантских бюджетов | Spine 2D Animation Basics for Beginners: Create Great Games on a Budget
Лепешкина Анна Викторовна

Энциклопедия кристаллов | Entsiklopediia kristallov
Холл Джоанна

Волшебные миры Хаяо Миядзаки | The Magical Worlds of Hayao Miyazaki
Нейпир Сюзан

Аниматор: набор для выживания. Секреты и методы создания анимации, 3D-графики и компьютерных игр | Animator's Survival Kit: Secrets and Methods for Creating Animation, 3D Graphics, and Computer Games
Сабанова Залина Олеговна

Студия Ghibli: творчество Хаяо Миядзаки и Исао Такахаты | Studio Ghibli: The Creativity of Hayao Miyazaki and Isao Takahata
Оделл Колин , …

Анимация кадр за кадром | Frame-by-Frame Animation
Альтендорфер Александр

Студия Ghibli. Все, что нужно знать о колыбели анимационных шедевров | Studio Ghibli: The Cradle of Animated Masterpieces

Мой сосед Хаяо. Артбук по мотивам творчества Миядзаки | My Neighbor Hayao: Artbook Inspired by Miyazaki's Work
Богданов Михаил Сергеевич

Ювелирные сокровища Российского императорского дворца | Jeweled Treasures of the Russian Imperial Court
Зимин Игорь Викторович , …

Anime Challenge. Блокнот настоящего отаку от Reanimedia | Anime Challenge. The Otaku's Notebook by Reanimedia

Психология украшений. Делай. Носи. Осознавай | The Psychology of Jewelry: Create. Wear. Be Mindful.
Ефимкина Римма Павловна

Скетчбук аниматора от Pixar | Pixar Animator's Sketchbook
Орлова Юлия Леонидовна
Digital Skills
Computer Science
Programming guides, IT textbooks and tech handbooks for students and professionals upgrading their craft.

Применение пакета MATLAB и SIMULINK для анализа электрических цепей. Том 2 | Application of MATLAB and SIMULINK for electrical circuit analysis. Volume 2
Фриск Валерий Владимирович , …

Компьютерный анализ переходных процессов в электрических цепях с помощью MATLAB (цветные иллюстрации) | Computer Analysis of Transient Processes in Electrical Circuits Using MATLAB (Color Illustrations)
Фриск Валерий Владимирович

В поисках эффекта. Планирование экспериментов и причинный вывод в статистике | In Search of the Effect: Experiment Planning and Causal Inference in Statistics
Хантингтон-Клейн Ник

Mathematica 5.1/5.2/6 в математических и научно-технических расчетах | Mathematica 5.1/5.2/6 in Mathematical and Scientific Computing
Дьяконов Владимир Павлович

Компьютерный спектральный анализ сигналов с помощью MATLAB | Computer Spectral Analysis of Signals Using MATLAB
Фриск Валерий Владимирович , …

MATLAB 6.5 SP1/7/7 SP1/7 SP2 + Simulink 5/6. Инструменты искусственного интеллекта и биоинформатики | MATLAB 6.5 SP1/7/7 SP1/7 SP2 + Simulink 5/6: AI and Bioinformatics Tools
Дьяконов Владимир Павлович

Применение пакета MATLAB для анализа резонансных явлений в электрических цепях (цветные иллюстрации) | Using MATLAB for Resonance Analysis in Electrical Circuits (Color Illustrations)
Фриск Валерий Владимирович

Регрессия: теория и практика. С примерами на R и Stan | Regression: Theory and Practice. With Examples in R and Stan
Гельман Э. , …

Моделирование и визуализация средствами MATLAB физики наноструктур | MATLAB Modeling and Visualization of Nanostructure Physics
Матюшкин Игорь Валерьевич

Визуализация данных с помощью ggplot2 | Data Visualization with ggplot2

MATLAB. Теория и практика. Учебное пособие | MATLAB. Theory and Practice. Textbook
Гилат Амос

Законы теории электрических цепей в матричной форме с примерами моделирования MATLAB | Matrix form laws of electrical circuits with MATLAB modeling examples
Фриск Валерий Владимирович

Практическая статистика для специалистов Data Science | Practical Statistics for Data Scientists
Брюс Питер , …

Статистика и планирование эксперимента для непосвященных | Statistics and Experiment Planning for Beginners
Майкл Х. Херцог , …
Why readers choose RusLibrary
From rare Soviet editions to fresh translations, RusLibrary curates the best of Russian literature with worldwide shipping and concierge-level support.
Books in our collection
Categories available
Countries served
Happy readers worldwide